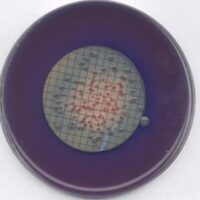
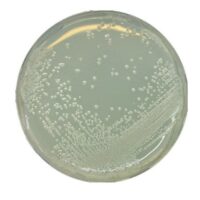
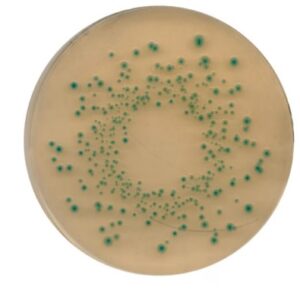
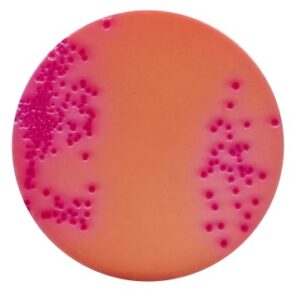
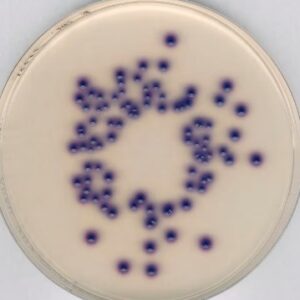
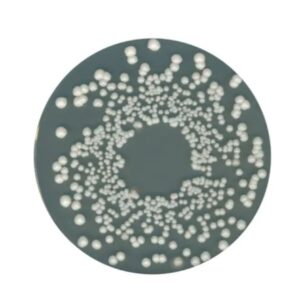
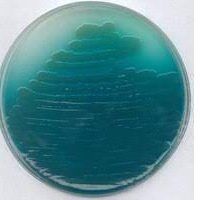
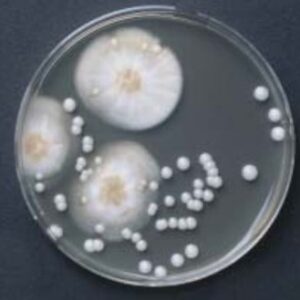
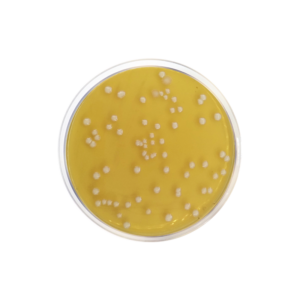

01 Food and Beverage Industry Lab
Ideal Medical Solutions provides sales and after sales support on Food Microbiological testing lab equipment.
We also provide after-sales support on environmental monitoring equipment to help keep your food facilities safe for convenient quality control
Showing 1–200 of 235 resultsSorted by popularity
-

Yeast Extract Powder 500g
R1,172.24 Add to cart -
![S-Pak® Filters, 0.45 µm, 47mm, white, gridded [Pack of 600]](https://idealmedical.co.za/wp/wp-content/uploads/2020/05/061-SPak-membranes-300x300.jpg)
S-Pak® Filters, 0.45 µm, 47mm, white, gridded [Pack of 600]
R5,867.06 Add to cart -
![Magic Wipes Cleaning Cloths [Pack of 50]](https://idealmedical.co.za/wp/wp-content/uploads/2022/05/396-Magic-wipes-300x300.jpg)
Magic Wipes Cleaning Cloths [Pack of 50]
R54.70 Select options This product has multiple variants. The options may be chosen on the product page -
![2,2,4-Trimethylpentane [2.5 Litres]](https://idealmedical.co.za/wp/wp-content/uploads/2023/02/689-trimethylpentane-300x300.jpg)
2,2,4-Trimethylpentane [2.5 Litres]
R4,008.51 Add to cart -

Lauryl Sulfate Broth for Microbiology, 500g
R2,423.70 Add to cart -

Skim Milk Powder 500g
R714.39 Add to cart -

Lysine Medium 500g
R1,706.60 Add to cart -
![S-Pak® Filters,with 3 pad dispensers and absorbent pads 0.45 µm, 47mm, white, Gridded [Pack of 600]](https://idealmedical.co.za/wp/wp-content/uploads/2020/05/061-SPak-membranes-300x300.jpg)
S-Pak® Filters,with 3 pad dispensers and absorbent pads 0.45 µm, 47mm, white, Gridded [Pack of 600]
R12,692.33 Add to cart -

Sterile bags for STOMACHER® blenders
R1,127.02 Add to cart -
![MilliporeSigma™ Sterile Absorbent Pads 47mm [Pack of 10 Canisters of 100 absorbent pads]](https://idealmedical.co.za/wp/wp-content/uploads/2023/01/674-Absorbent-pads-300x300.jpg)
MilliporeSigma™ Sterile Absorbent Pads 47mm [Pack of 10 Canisters of 100 absorbent pads]
R5,765.86 Add to cart -

Silicone Rotational Viscosity Standard 600ml
R5,242.76 Select options This product has multiple variants. The options may be chosen on the product page -

Blood Agar (Base) 500g
R2,274.37 Add to cart -

Potato Dextrose Agar, PDA 500g
R1,734.77 Add to cart -

Brila (Brilliant Green Bile Lactose) Broth
R5,601.57 Add to cart -

W. L. Nutrient Medium 500g
R1,729.89 Add to cart -

2,3,5-Triphenyltetrazolium chloride
R1,922.56 R10,423.20Price range: R1,922.56 through R10,423.20 Select options This product has multiple variants. The options may be chosen on the product page -

Tryptic Soy Broth 500g
R2,026.07 Add to cart -

Mac Conkey Agar, 500g
R1,503.94 R1,990.00Price range: R1,503.94 through R1,990.00 Select options This product has multiple variants. The options may be chosen on the product page -
![MacConkey Agar Contact Plate 55mm [Pack of 20]](https://idealmedical.co.za/wp/wp-content/uploads/2020/06/084-Contact-Agar-Plate-200x200.jpg)
MacConkey Agar Contact Plate 55mm [Pack of 20]
R1,403.68 Add to cart -

Anaerocult™ C
R2,033.95 Add to cart -

Sterility Indicator (Steam Sterilization)
R877.60 Add to cart -
![Bactident™ Coagulase [6 x 3mL]](https://idealmedical.co.za/wp/wp-content/uploads/2023/11/973-Coagulese-200x200.jpg)
Bactident™ Coagulase [6 x 3mL]
R2,866.72 Add to cart -

Beef extract powder 500g
R8,417.65 Add to cart -

Tetrahydrofuran anhydrous,inhibitor-free, suitable for HPLC, ≥99.9%
R2,394.42 R6,065.42Price range: R2,394.42 through R6,065.42 Select options This product has multiple variants. The options may be chosen on the product page -

Hydrogen peroxide solution 3%, (Catalase Test) 100ml
R768.01 Add to cart -

Brain Heart Infusion Agar 500g
R2,514.70 Add to cart -

Brilliant Green Bile Lactose Broth 500g
R6,110.53 Add to cart -

ReadyPlate™ CT VRBG (Violet Red Bile Glucose) Agar
R1,392.96 Add to cart -

Certipur®Standard Reference Materials for Photometric/ Chromatography Applications
R1,033.08 R6,608.84Price range: R1,033.08 through R6,608.84 Select options This product has multiple variants. The options may be chosen on the product page -
![HY-LiTE® Hygiene Swab [Pack of 50]](https://idealmedical.co.za/wp/wp-content/uploads/2022/05/436-hylite-swab-300x300.jpg)
HY-LiTE® Hygiene Swab [Pack of 50]
R932.72 Add to cart -

Fridge Thermometer, Digital
R527.17 Add to cart -

Tryptone Soy Broth (Caso Broth) 500g
R2,019.38 Add to cart -

Lab Incubator Maintenance and Repair
R500.00 R2,500.00Price range: R500.00 through R2,500.00 Select options This product has multiple variants. The options may be chosen on the product page -
![Tryptic Soy Agar + LTHTh - ICR, 90mm settle plates [Pack of 20]](https://idealmedical.co.za/wp/wp-content/uploads/2020/06/136-Tryptic-soy-ICR-300x300.jpg)
Tryptic Soy Agar + LTHTh – ICR, 90mm settle plates [Pack of 20]
R1,774.56 Add to cart -

ReadyPlate™55 Chromocult® m-Green Agar
R855.38 Add to cart -
![ReadyPlate™ 55 Chromocult® Coliform Agar plate, 55 mm, for Escherichia coli, for coliforms [Pack of 20]](https://idealmedical.co.za/wp/wp-content/uploads/2020/05/027-Agar-plates-300x300.jpg)
ReadyPlate™ 55 Chromocult® Coliform Agar plate, 55 mm, for Escherichia coli, for coliforms [Pack of 20]
R1,076.40 Add to cart -

MRS Agar (Lactobacillus Agar), 500g
R1,919.49 Add to cart -

Middlebrook 7H10 Agar Base
R7,633.48 Add to cart -

Middlebrook 7H9 Broth Base
R7,670.26 Add to cart -

MKTTn Novobiocin Supplement
R2,492.05 Add to cart -

ReadyPlate™ Mannitol Egg Yolk Polymyxin Agar, 90 mm plate
R1,779.66 Add to cart -

Mac Conkey-Sorbitol ChromoSelect Agar
R13,415.59 Add to cart -

MUG EC broth
R10,838.47 Add to cart -

Malt Extract Broth
R2,316.89 Add to cart -

Mitis Salivarius Agar
R3,430.34 Add to cart -

Legionella (GVPC) Selective Supplement
R3,868.25 Add to cart -

Mueller Hinton Broth
R3,957.74 Add to cart -

Tryptic Soy Agar
R2,304.72 Add to cart -

Kligler Agar
R1,472.24 Add to cart -

Dissolved Oxygen certified reference material
R2,261.92 Add to cart -

Pseudomonas CN Selective Supplement
R6,110.11 Add to cart -

Nocive Brewers Bacteria Agar Base
R4,118.09 Add to cart -

Luria Bertani Agar
R3,457.07 Add to cart -

Urea (BUN) Quick Test Strips
R2,508.44 Add to cart -

Proteose-Peptone
R4,533.57 Add to cart -

Marine Broth 2216
R3,807.02 Add to cart -

Beef extract powder
R10,214.55 Add to cart -

Millipore Absorbant Pad Dispenser with 2 Canisters
R2,464.83 Add to cart -

Oatmeal agar
R4,438.15 Add to cart -

Proteose Peptone (vegetable) 500g
R2,614.41 Add to cart -

Universal Differential ChromoSelect Medium
R6,892.00 Add to cart -

PLET Agar
R2,936.63 Add to cart -

Geobacillus stearothermophilus Spore Suspension
R4,085.60 Add to cart -

Yeast Extract for technical purposes (in fermentation)
R1,923.46 Add to cart -

Singlepath® Campylobacter Rapid Test
R6,197.74 Add to cart -

Pyrase Strips for microbiology
R1,685.39 Add to cart -

Cellobiose Polymyxin Colistin (CPC) Agar
R5,583.00 Add to cart -

TOS-propionate agar medium
R5,234.68 Add to cart -

Toluene suitable for HPLC, 99.9%
R6,034.18 Add to cart -

MUG Supplement
R3,032.53 Add to cart -

Methanol
R589.09 R2,000.01Price range: R589.09 through R2,000.01 Select options This product has multiple variants. The options may be chosen on the product page -

Protease from Bacillus licheniformis
R4,685.42 R18,769.29Price range: R4,685.42 through R18,769.29 Select options This product has multiple variants. The options may be chosen on the product page -

Nitrate Broth
R3,564.17 Add to cart -

Litmus Milk 500g
R1,830.61 Add to cart -

Phenol red broth base 500g
R5,867.32 Add to cart -

HY-LiTE® ATP Standard Solution
R3,919.23 Add to cart -

HY-LiTE® 2 Hygiene Monitoring System
R186,367.24 Add to cart -

Muller-Kauffmann Tetrathionate Novobiocin Broth 500g
R2,802.07 Add to cart -

Perfringens Agar Base 500g
R3,543.47 Add to cart -

Petri dish, sterile, Single use, diam. 47 mm, Millipore
R5,498.19 Add to cart -
![Thimble cellulose, size 33 mm × 94 mm [Pack of 25]](https://idealmedical.co.za/wp/wp-content/uploads/2023/09/909-Thimble-200x200.jpg)
Thimble cellulose, size 33 mm × 94 mm [Pack of 25]
R4,998.77 Add to cart -
![Glucose (GO) Assay Kit [sufficient for 20 assays]](https://idealmedical.co.za/wp/wp-content/uploads/2023/08/892-GO-assay-kit-200x200.jpg)
Glucose (GO) Assay Kit [sufficient for 20 assays]
R2,668.38 Add to cart -

Membrane Lactose Glucuronide Agar 500g
R13,930.08 Add to cart -
m-FC Agar 500g
R1,478.72 Add to cart -
BAT agar 500g
R11,334.84 Add to cart -

N-Z-Amine® A Casein enzymatic hydrolysate 500g
R3,083.40 Add to cart -
![Optochin Disks [50 Discs]](https://idealmedical.co.za/wp/wp-content/uploads/2023/08/875-Optochin-disc-200x200.jpg)
Optochin Disks [50 Discs]
R771.13 Add to cart -

Brilliant green agar, modified 500g
R4,962.96 Add to cart -
![MC-Media Pad® for E.Coli and Coliforms [Pack of 100]](https://idealmedical.co.za/wp/wp-content/uploads/2023/08/859-MC-media-pad-200x200.jpg)
MC-Media Pad® for E.Coli and Coliforms [Pack of 100]
R5,079.38 Add to cart -
![m-ColiBlue24 Broth [50 x 2mL]](https://idealmedical.co.za/wp/wp-content/uploads/2023/08/856-mcoli-blue-200x200.jpg)
m-ColiBlue24 Broth [50 x 2mL]
R4,567.73 Add to cart -

Enterococcus Selective Agar 500g
R4,590.56 Add to cart -
![Bacitracin Discs [Pack of 50]](https://idealmedical.co.za/wp/wp-content/uploads/2023/07/809-Bacitracin-discs-200x200.jpg)
Bacitracin Discs [Pack of 50]
R673.13 Add to cart -
Tryptone Bile X-glucuronide agar 500g
R9,935.14 Add to cart -

Nocive Brewers Bacteria Agar Base, modified 500g
R2,989.29 Add to cart -

Deoxycholate citrate agar 500g
R7,164.76 Add to cart -
![Vanillin 99% [500g]](https://idealmedical.co.za/wp/wp-content/uploads/2023/06/755-Vanillin-300x300.jpg)
Vanillin 99% [500g]
R2,903.38 Add to cart -
![Antibiotic Agar No 2 [500g]](https://idealmedical.co.za/wp/wp-content/uploads/2023/06/748-Antibiotic-agar-2-200x200.jpg)
Antibiotic Agar No 2 [500g]
R3,981.46 Add to cart -
![Acetonitrile, ≥99.9% for HPLC [2.5L]](https://idealmedical.co.za/wp/wp-content/uploads/2023/06/741-Acetonitrile-200x200.jpg)
Acetonitrile, ≥99.9% for HPLC [2.5L]
R8,255.76 Add to cart -

Hektoen Enteric Agar 500g
R3,374.26 Add to cart -
![Petri dish, sterile, Single use, diam. 47 mm, Millipore [Pack of 600]](https://idealmedical.co.za/wp/wp-content/uploads/2023/06/736-petri-millipore-300x300.jpg)
Petri dish, sterile, Single use, diam. 47 mm, Millipore [Pack of 600]
Read more -

Peptone salt solution (Maximum recovery diluent) 500g
R2,061.98 Add to cart -

Rappaport Vassiliadis Broth, modified 500g
R3,087.02 Add to cart -

Enterococci ChromoSelect Broth 500g
R5,013.93 Add to cart -

Bacillus ChromoSelect Agar 500g
R3,260.78 Add to cart -
![HY-LiTE® Surface ATP Test Kit [100 Tests]](https://idealmedical.co.za/wp/wp-content/uploads/2023/04/710-Hylite-300x300.jpg)
HY-LiTE® Surface ATP Test Kit [100 Tests]
R14,364.36 Add to cart -
![Urea solution 40% [10 vials]](https://idealmedical.co.za/wp/wp-content/uploads/2023/04/700-Urea-Solution-40-300x300.jpg)
Urea solution 40% [10 vials]
R1,345.86 Add to cart -

Cooked Meat Broth 500g
R4,233.47 Add to cart -
Yersinia Selective Agar 500g
R3,263.41 Add to cart -
![Thayer-Martin Supplement II [2 units]](https://idealmedical.co.za/wp/wp-content/uploads/2023/03/693-thayer-martin-supplement-1-and-2-200x200.jpg)
Thayer-Martin Supplement II [2 units]
R1,182.55 Add to cart -
![Thayer-Martin Supplement I [2 Vials]](https://idealmedical.co.za/wp/wp-content/uploads/2023/03/693-thayer-martin-supplement-1-and-2-200x200.jpg)
Thayer-Martin Supplement I [2 Vials]
R1,106.44 Add to cart -

Thayer Martin Agar (Base) 500g
R2,794.71 Add to cart -
Coliform Agar 500g, Chromocult®
R16,416.98 Add to cart -

1-Naphthol, ≥99%
R3,226.86 R10,858.60Price range: R3,226.86 through R10,858.60 Select options This product has multiple variants. The options may be chosen on the product page -
Orange Serum agar 500g
R7,097.48 Add to cart -

M-TGE Broth pack of 50 × 2 mL
R2,642.07 Add to cart -
![Whatman Sterile OmniSwab [Pack of 100]](https://idealmedical.co.za/wp/wp-content/uploads/2022/12/981-Omniswab-200x200.jpg)
Whatman Sterile OmniSwab [Pack of 100]
R6,103.23 Add to cart -
Pseudomonas Isolation Agar 500g
R3,629.95 Add to cart -

Brain Heart Infusion broth 500g
R4,527.03 Add to cart -
![Lactose TTC Agar with Tergitol™ 7 [500g]](https://idealmedical.co.za/wp/wp-content/uploads/2022/10/618-t-300x300.jpg)
Lactose TTC Agar with Tergitol™ 7 [500g]
R5,354.72 Add to cart -

Escherichia Coli (EC) Broth 500g
R4,803.69 Add to cart -
![Singlepath® Listeria monocytogenes Rapid L. Mono Food Test [25 Tests]](https://idealmedical.co.za/wp/wp-content/uploads/2022/10/617-Singlepath-listeria-300x300.jpg)
Singlepath® Listeria monocytogenes Rapid L. Mono Food Test [25 Tests]
R5,689.86 Add to cart -
![VIP® Gold Salmonella Rapid Test kit [40 Tests]](https://idealmedical.co.za/wp/wp-content/uploads/2022/10/729-Gold-salmonella-200x200.jpg)
VIP® Gold Salmonella Rapid Test kit [40 Tests]
R7,453.67 Add to cart -

Legionella Agar Base 500g
R5,118.05 Add to cart -

Plate Count Agar 500g (Suitable for use in Halal certified processes)
R6,097.23 Add to cart -

Selenite Broth (Base) 500g
R3,688.59 Add to cart -
![Chloramphenicol Selective Supplement [Pack of 5 vials]](https://idealmedical.co.za/wp/wp-content/uploads/2022/09/591-chloramphenicol-supplement-200x200.jpg)
Chloramphenicol Selective Supplement [Pack of 5 vials]
R1,563.69 Add to cart -
![Clostridium perfringens selective supplement [Pack of 10 vials]](https://idealmedical.co.za/wp/wp-content/uploads/2022/09/590-tsc-agar-supplement-300x300.jpg)
Clostridium perfringens selective supplement [Pack of 10 vials]
R7,724.11 Add to cart -

Mannitol egg yolk polymyxin (MYP) agar base 500g
R5,664.79 Add to cart -

CombiCoulomat fritless 500ml
R4,416.20 Add to cart -
![1-Decanol [1 Litre]](https://idealmedical.co.za/wp/wp-content/uploads/2022/08/572-decanol-200x200.jpg)
1-Decanol [1 Litre]
R1,128.21 Add to cart -

CombiCoulomat frit 500ml
R3,539.00 Add to cart -
![Titrant 5 [2.5 Litres]](https://idealmedical.co.za/wp/wp-content/uploads/2022/08/571-titrant-5-200x200.jpg)
Titrant 5 [2.5 Litres]
R3,973.69 Add to cart -

CombiSolvent Fats 1L
R3,067.72 Add to cart -

CombiTitrant 5
R3,485.56 R7,427.62Price range: R3,485.56 through R7,427.62 Select options This product has multiple variants. The options may be chosen on the product page -

Determination of Water Content in Sunflower Oil Using Karl Fischer Titration
R1,128.21 R4,416.20Price range: R1,128.21 through R4,416.20 View products -

YPD ( Yeast Extract Peptone Dextrose) Agar
R2,011.19 R5,932.91Price range: R2,011.19 through R5,932.91 Select options This product has multiple variants. The options may be chosen on the product page -

Yeast Synthetic Drop-out Medium Supplements 20g
R2,294.54 R5,863.74Price range: R2,294.54 through R5,863.74 Select options This product has multiple variants. The options may be chosen on the product page -
![Ringer Tablets [100 Tablets]](https://idealmedical.co.za/wp/wp-content/uploads/2022/08/562-ringer-tablets-300x300.jpg)
Ringer Tablets [100 Tablets]
R1,258.35 Add to cart -
OGYE agar, Base 500g
R4,746.90 Add to cart -
Raka Ray Agar 500g
R4,485.26 Add to cart -

Mycoplasma agar base 500g
R5,043.68 Add to cart -

Corn Meal Agar (CMA) 500g
R4,612.82 Add to cart -

Potato Dextrose Broth
R3,005.96 R8,600.23Price range: R3,005.96 through R8,600.23 Select options This product has multiple variants. The options may be chosen on the product page -

Tomato Juice Agar 500g
R4,413.66 Add to cart -

MF-Millipore® Membrane Filter, 0.45 µm pore size, gridded
R3,959.57 R8,215.37Price range: R3,959.57 through R8,215.37 Select options This product has multiple variants. The options may be chosen on the product page -

Methanol, suitable for HPLC
R1,104.22 R1,613.44Price range: R1,104.22 through R1,613.44 Select options This product has multiple variants. The options may be chosen on the product page -

Thiosulfate Citrate Bile Sucrose (TCBS) Agar 500g
R3,506.41 Add to cart -

Ethyl Violet Azide (EVA) Broth 500g
R2,419.48 Add to cart -

YGC Agar (Yeast Extract Glucose Chloramphenicol Agar FIL-IDF) 500g
R6,979.35 Add to cart -
![Yeast Glucose Chloramphenicol Agar [6x 200ml]](https://idealmedical.co.za/wp/wp-content/uploads/2022/08/516-YGC-Agar-200x200.jpg)
Yeast Glucose Chloramphenicol Agar [6x 200ml]
R1,162.90 Add to cart -

Tryptone Glucose Extract Agar 500g
R3,804.68 Add to cart -
![Bactident™ E. coli [50 Tests]](https://idealmedical.co.za/wp/wp-content/uploads/2022/08/514-Bactident-ecoli-200x200.jpg)
Bactident™ E. coli [50 Tests]
R3,972.71 Add to cart -

Universal Beer Agar 500g
R3,441.31 Add to cart -

Anaerobic agar, Wilkins Chalgren 500g
R6,977.65 Add to cart -

DNase test agar with toluidine blue 500g
R13,040.75 Add to cart -

Motility Test Medium, 500g
R7,292.70 Add to cart -

Triple Sugar Iron Agar 500g
R4,065.49 Add to cart -

Tryptone water 500g
R4,569.83 Add to cart -
![Litmus Red Paper, Johnson [ 10 books of 20 strips]](https://idealmedical.co.za/wp/wp-content/uploads/2022/05/399-Johnson-litmus-papers-300x300.jpg)
Litmus Red Paper, Johnson [ 10 books of 20 strips]
R440.12 Add to cart -
![HY-RiSE® Color Hygiene Test Strip [Pack of 50]](https://idealmedical.co.za/wp/wp-content/uploads/2022/06/460-hy-rise-rapid-test-hygiene-200x200.jpg)
HY-RiSE® Color Hygiene Test Strip [Pack of 50]
R7,029.08 Add to cart -

Melting point standard 121-123°C, analytical standard 5g
R722.94 Add to cart -

Melting point standard 182-184°C, analytical standard
R576.40 R1,080.50Price range: R576.40 through R1,080.50 Select options This product has multiple variants. The options may be chosen on the product page -

Melting point standard 47-49°C, analytical standard
R455.02 R983.03Price range: R455.02 through R983.03 Select options This product has multiple variants. The options may be chosen on the product page -

Melting point standard 79-81°C, analytical standard 1g
R991.20 Add to cart -

Melting point standard 235-237°C, analytical standard
R455.02 R991.20Price range: R455.02 through R991.20 Select options This product has multiple variants. The options may be chosen on the product page -

Melting point standard 283-286°C, analytical standard 1g
R3,208.30 Add to cart -

Sulfuric acid 25%, 1 Litre
R712.41 Add to cart -

Motility Indole Ornithine Medium, 500g
R5,229.15 Add to cart -

Tryptic Soy Agar (TSA) Contact Plates, 55mm
R1,814.86 R13,369.64Price range: R1,814.86 through R13,369.64 Select options This product has multiple variants. The options may be chosen on the product page -
![Whatman® quantitative filter paper, ashless, Grade 43, circles [Pack of 100]](https://idealmedical.co.za/wp/wp-content/uploads/2022/05/434-Whatman-43-200x200.jpg)
Whatman® quantitative filter paper, ashless, Grade 43, circles [Pack of 100]
R881.66 R2,429.26Price range: R881.66 through R2,429.26 Select options This product has multiple variants. The options may be chosen on the product page -
![ReadyPlate™55 KIT TGE (Tryptone Glucose Extract) Agar [Pack of 150]](https://idealmedical.co.za/wp/wp-content/uploads/2022/05/024-Agar-plates-55mm-300x300.jpg)
ReadyPlate™55 KIT TGE (Tryptone Glucose Extract) Agar [Pack of 150]
R13,759.43 Add to cart -

Prove 600 UV/ VIS Spectrophotometer Spectroquant®
R236,618.30 Add to cart -
![Millex Syringe Filter, Glass Fiber, Non-sterile [Pack of 50]](https://idealmedical.co.za/wp/wp-content/uploads/2022/05/420-millex-filter-200x200.png)
Millex Syringe Filter, Glass Fiber, Non-sterile [Pack of 50]
R2,728.95 Add to cart -

Bromate in water and drinking water – ultra low range (Photometric)
R838.58 R199,497.19Price range: R838.58 through R199,497.19 View products -

mTSB Broth with Novobiocin, 500g
R3,821.62 Add to cart -

Modified tryptone soy broth, 500g
R2,069.89 Add to cart -

Simmons Citrate Agar, 500g
R4,900.46 Add to cart -

Campylobacter Selective Agar (Base), 500g
R6,880.03 Add to cart -
![Litmus Blue Paper, Johnson [ 10 books of 20 strips]](https://idealmedical.co.za/wp/wp-content/uploads/2022/05/399-Johnson-litmus-papers-300x300.jpg)
Litmus Blue Paper, Johnson [ 10 books of 20 strips]
R322.52 Add to cart -
![pH Indicator paper, Johnson [10 books of 20 strips]](https://idealmedical.co.za/wp/wp-content/uploads/2022/05/398-Indicator-paper-1-to-11-300x300.jpg)
pH Indicator paper, Johnson [10 books of 20 strips]
R479.34 Add to cart -
![Nitrite Cell Test Spectroquant® [25 Tests]](https://idealmedical.co.za/wp/wp-content/uploads/2022/05/395-Nitrite-spectrouant-200x200.jpg)
Nitrite Cell Test Spectroquant® [25 Tests]
R4,024.64 R4,195.61Price range: R4,024.64 through R4,195.61 Select options This product has multiple variants. The options may be chosen on the product page -

Sucrose for molecular biology
R2,163.56 Add to cart -

Wort Agar
R4,092.95 Add to cart -

CLED Agar 500g
R3,457.22 Add to cart -

Violet Red Bile MUG Agar 500g
R4,041.87 Add to cart -

SABOURAUD-2% dextrose broth 500g
R1,377.54 Add to cart -
![pH-indicator paper pH 1 - 14 Universal indicator MQuant®[Pack of 3 rolls]](https://idealmedical.co.za/wp/wp-content/uploads/2022/04/1511-pH-indicator-paper-200x200.jpg)
pH-indicator paper pH 1 – 14 Universal indicator MQuant®[Pack of 3 rolls]
R1,507.90 Add to cart -
![HY-LiTE® Liquid Test Pens for Total ATP [Pack of 50]](https://idealmedical.co.za/wp/wp-content/uploads/2022/02/373-hylite-test-pens-300x300.jpg)
HY-LiTE® Liquid Test Pens for Total ATP [Pack of 50]
R6,659.28 Add to cart -

Spectroquant Prove UV/VIS Spectrophotometer Service
R3,000.00 R7,400.00Price range: R3,000.00 through R7,400.00 Select options This product has multiple variants. The options may be chosen on the product page -

1-Naphthol , ≥99%
R3,213.49 R10,714.79Price range: R3,213.49 through R10,714.79 Select options This product has multiple variants. The options may be chosen on the product page -

Spectroquant® Prove 300 Plus VIS Spectrophotometer
R199,497.19 Add to cart -

Spectroquant® Nitrate Photometric Tests
R3,927.05 R10,476.22Price range: R3,927.05 through R10,476.22 Select options This product has multiple variants. The options may be chosen on the product page -

Aluminium Photometric Test
R3,774.90 R5,715.21Price range: R3,774.90 through R5,715.21 Select options This product has multiple variants. The options may be chosen on the product page -
![Acid Capacity Cell Test to pH 4.3 (total alkalinity) [120 Tests]](https://idealmedical.co.za/wp/wp-content/uploads/2020/07/227-Cell-Test-Kits-300x300.jpg)
Acid Capacity Cell Test to pH 4.3 (total alkalinity) [120 Tests]
R5,223.51 Add to cart -

Beviflex Unit, 100mL funnel, 0.45µm black gridded
R2,717.07 Add to cart -
![Clear Fluid Thioglycollate in bottle with screw cap and septum [Pack of 12]](https://idealmedical.co.za/wp/wp-content/uploads/2020/06/096-sterility-media_1-300x300.jpg)
Clear Fluid Thioglycollate in bottle with screw cap and septum [Pack of 12]
R1,307.71 Add to cart -
![Malt Extract Contact Agar- Room Temp [Pack of 20]](https://idealmedical.co.za/wp/wp-content/uploads/2020/06/084-Contact-Agar-Plate-200x200.jpg)
Malt Extract Contact Agar- Room Temp [Pack of 20]
R1,106.08 Add to cart -

MAS-100 Eco® Air Sampler for Food Industry
R165,064.75 Add to cart
![PetriSlides for contamination analysis [Pack of 100]](https://idealmedical.co.za/wp/wp-content/uploads/2020/07/156-Petri-slides-for-contamination-analysis-300x300.jpg)
![PetriSlides dish preloaded with absorbent pads [Pack of 100]](https://idealmedical.co.za/wp/wp-content/uploads/2020/07/155-Petri-slides-300x300.jpg)